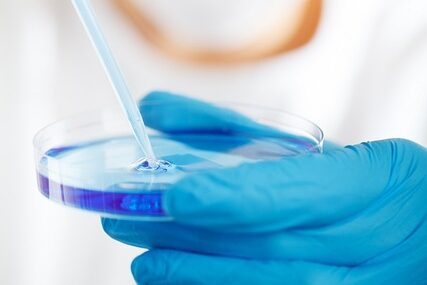

Organoids Are Us 2025
Glasgow, Scotland, United KingdomSeptember 23-26, 2025 Glasgow, Scotland, United Kingdom
 Cancer Stem Cell News
Cancer Stem Cell News Cell Therapy News
Cell Therapy News Dermal Cell News
Dermal Cell News Endothelial Cell News
Endothelial Cell News ESC & iPSC News
ESC & iPSC News Extracellular Matrix News
Extracellular Matrix News Hematopoiesis News
Hematopoiesis News Hepatic Cell News
Hepatic Cell News Human Immunology News
Human Immunology News Immune Regulation News
Immune Regulation News
 Intestinal Cell News
Intestinal Cell News Mammary Cell News
Mammary Cell News Mesenchymal Cell News
Mesenchymal Cell News Muscle Cell News
Muscle Cell News Neural Cell News
Neural Cell News Organoid News
Organoid News Pancreatic Cell News
Pancreatic Cell News Prostate Cell News
Prostate Cell News Pulmonary Cell News
Pulmonary Cell News Cancer Stem Cell News
Cancer Stem Cell News Cell Therapy News
Cell Therapy News Dermal Cell News
Dermal Cell News Endothelial Cell News
Endothelial Cell News ESC & iPSC News
ESC & iPSC News Extracellular Matrix News
Extracellular Matrix News Hematopoiesis News
Hematopoiesis News Hepatic Cell News
Hepatic Cell News Human Immunology News
Human Immunology News Immune Regulation News
Immune Regulation News
 Intestinal Cell News
Intestinal Cell News Mammary Cell News
Mammary Cell News Mesenchymal Cell News
Mesenchymal Cell News Muscle Cell News
Muscle Cell News Neural Cell News
Neural Cell News Organoid News
Organoid News Pancreatic Cell News
Pancreatic Cell News Prostate Cell News
Prostate Cell News Pulmonary Cell News
Pulmonary Cell News
September 23-26, 2025 Glasgow, Scotland, United Kingdom

September 24-27, 2025 Montreal, Quebec, Canada

September 24-27, 2025 Cold Spring Harbor, New York, United States
September 28-October 1, 2025 St. Julian's, Malta

September 28-October 1, 2025 Cold Spring Harbor, New York, United States

October 1-4, 2025St. Julians, Malta

October 5-9, 2025 Honolulu, Hawaii, United States

October 7-10, 2025 St. Julian's, Malta

October 9-10, 2025 Leuven, Belgium

October 10-13, 2025 St. Julian's, Malta

October 22-25, 2025 Heidelberg, Germany & Online

October 22-26, 2025 Boston, Massachusetts, United States
